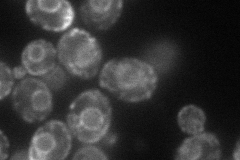
YGL051W
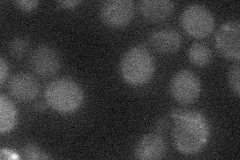
YGL051W
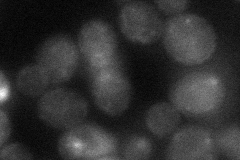
YGL051W

View description
Putative integral membrane protein, involved in vesicle formation; forms complex with Mst28p; member of DUP240 gene family; binds COPI and COPII vesicles
Localization:
Intensity:
Fold change:
Significance:
-
C’ GFP library in SD

below threshold17.32 -
N' NOP1pr-GFP in SD
ER,punctate65.3295 -
N' TEF2pr-mCherry in SD

ER135.45 -
N' NATIVEpr-GFP in SD
below threshold17.0954 -
N' TEF2pr-VC and Cyto-VN in SD
ER,punctate35.0478 -
C’ GFP library in SD+DTT

cytosol17.841.02No -
C’ GFP library in SD+H2O2

cytosol14.650.84No -
C’ GFP library in Starvation Media

cytosol16.890.97No -
C’ GFP library on the background of Pup2-DaMP

below threshold -
C’ GFP library on the background of CCT mutant

below threshold18.39781.06204No
